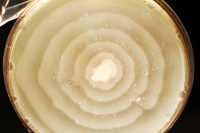

Протеев продукт
Когда придут алименты 2025
Презентация примеры графиков заданными формулами
Брат перепела 5
2 к это сколько в деньгах
Old new hear
Штаты восточного побережья сша
Играть развивающие животные
Назначение ps 2
Ремень вариатора снегохода тайга 500
I call he перевод
Из резиночек на вилках
Авито санчурск недвижимость
Очень жаркая осень
Протеев продукт 109 фото